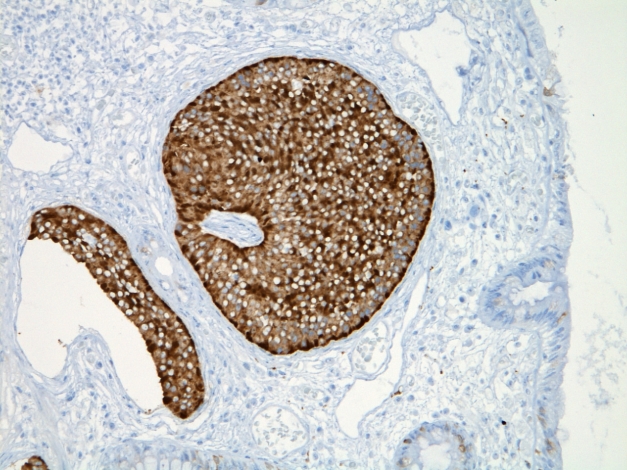

免疫組織化学染色標本
顕微鏡写真サンプル
当研究所で作製した免疫染色標本の
顕微鏡写真サンプルです。
ここに掲載している免疫染色(一次抗体)は
弊社で実施可能な免疫染色のほんの一部です。
CD3

写真: リンパ節 ×400
CD20(L26)

写真: リンパ節 ×400
CD68

写真: 肺 ×400
CD79a

写真: リンパ節 ×400
CD138

写真: 皮膚 ×400
CD163

写真: 肺 ×400
CK7

写真: 肺 ×400
Ki-67(TEC-3)

写真: 肺 ×400
MUC1

写真: 大腸 ×200
MUC2

写真: 大腸 ×200
p53

写真: 胃 ×200
p63

写真: 皮膚 ×200
PE10

写真: 肺 ×400
Synaptophysin
写真: 大腸 ×200
お問い合わせ
病理組織検査や病理標本作製など、弊社の受託サービスに関してご不明な点がございましたら どうぞお気軽にお問い合わせくださいませ。
E-mailはこちらをクリックしてください
